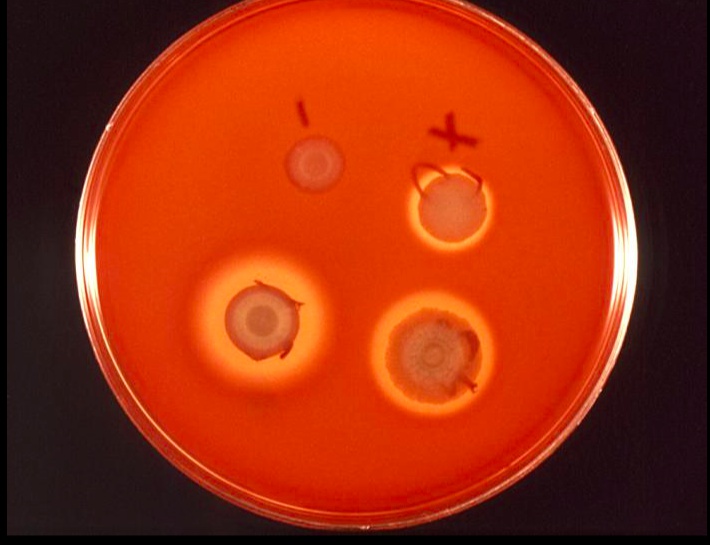
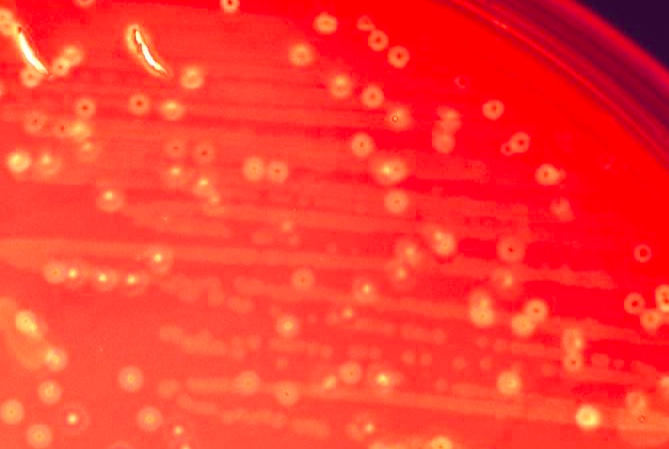
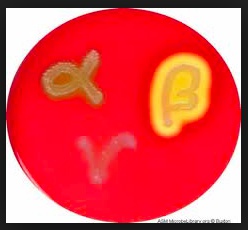

01 Gm Positive Cocci
_..

beta, clear halo
alpha, green halo, from oxidation of hemoglobin

Staph Aureus
_..

Purple cloth: gram positive
Egyptian cat: Catalase Positive
Moses parting sea: Coagulase positive
Light bulb red: Beta hemolytic
Tall man: Ferments mannitol salt, turns yellow
A staph: Protein A binds Fc portion of IgG.,

Egyptian nose: Colonizes nares.,

_..

Running camel and mortar/pestel: acute rapid onset tricuspid endocarditis in IV drug users
Running camel with women nauseating: Fast onset food poisoning, meats/mayonnaise
Fish bones: Osteomyelitis
Red camel humps: Abscess formation
2 dices: Icosahedral shaped virus, post viral URI pneumonia
Coughing and patchy clothes: Pneumonia: patchy infiltrate on CXR
Bald man burned: Scalded skin syndrome: exfoliative toxin
Lightning cape with shock: TSST (acts as super antigen) causes toxic shock syndrome
Kneeling, joints: Septic arthritis
_..

Pharoah: MRSA (mercy)
Altered PBP workers: Altered penicillin binding protein (allows methicillin resistance)
Caravan: Vancomycin for treatment if MRSA
_..

Pencil: Nafcillin for Staph infections (not MRSA)
Staph Epidermis and Sapro
_..

Purple curtains: Gm +
Bowl of jelly untouched: Coagulase negative
Cat: Catalase positive
NH3 bottle: Urease positive
Navel exposed: S. epidermidis is novobiocin sensitive
Navel not exposed: S. saprophyticus is novobiocin resistant
_..

Plumber working: staph epidermis associated with prosthetic joint infection and catheters
Heart shaped valve: Associated with prosthetic valve infection
Green gunk: Staph epidermis produces thick biofilms that adhere to prosthetic surfaces
Dirty pan: Staph epidermis commonly contaminates blood cultures
Dirt on plumber's hands: staph epidermis part of normal skin flora
_..

Van: Vancomycin may be used to treat staph epidermis
_..

Sexy girl with UTI cup: S. saprophyticus is a common cause of UTI in sexually active females
Strep Pyogenes
_aka GAS.,
_..

Hot Apple under container: Hyaluronic Acid capsule
B bulb: Beta hemolytic
Baci hound eating bread: Bacitracin sensitive
S pyogenes are catalase-negative, β-hemolytic, gram-positive cocci in chains. S pyogenes is unique among β-hemolytic streptococci as it is susceptible to bacitracin. Because the bacitracin test is not very specific for S pyogenes, it has been replaced in many laboratories by the pyrrolidonyl arylamidase (PYR) test; S pyogenes is PYR-positive.
_..

Honey crusted lemon pie: Impetigo
Red gloves: cellulitis and erysipelas
Red bandana: Pharyngitis

_..

scarlet fever: erythrogenic toxin
Strep-TSST (acts as super antigen) causes Streptococcal Toxic Shock Syndrome
Burnt ginger with legs falling off: Necrotizing Fasciitis (Exotoxin B)
_..

(erythrogenic toxin)
Sticking tongue out and lick strawberry: Strawberry tongue
Red bandana: Pharyngitis
Ginger: diffused rash sparing face


_..

rheumatic fever: master chef with M
PSGN: post strep glomerulonephritis: chef on phone
Rheumatic Fever
_..

M hat and prevent stealing: M protein: prevents phagocytosis
Mitral hat: Endocarditis: affects mitral valve; M protein molecular mimicry with muscle myosins. Mitral stenosis
anti-M protein antibodies cause Rheumatic Fever
Red bandana: Pharyngitis precipitates RF, especially in children
Jones criteria
_..

Jones criteria for RF: Joints (polyarthritis). Frosting on elbow
Jones criteria for RF: heart (carditis). Valvular, myocarditis, pericarditis
Jones criteria for RF: Nodules (Subcutaneous nodules)
Jones criteria for RF: Erythema Marginatum, rash with thick red borders
Jones criteria for RF: Sydenham's Chorea, rapid involuntary movement of hands and face

erythema marginatum
PSGN
_..

Post-strep glomerulonephritis (PSGN)
Chef talking on phone: glomerulonephritis from antigen-antibody deposition (type III )
Facial puffs: Facial swelling seen in PSGN
Cola: Cola colored urine with PSGN
Calendar: PSGN occurs 2 weeks after Strep infection
RF Vs PSGN
_..

red bandana: both can happen with strep pharyngitis
honey crumbs: PSGN most common after superficial skin infection (impetigo). In contrast to Acute RF which requires Strep pharyngitis.
Pencil: Early penicillin for treatment (prevents RF but not PSGN). Even though chef has pencil, he still has symptoms
_..

O shaped doughnuts leaking: Streptolysin O, lysis RBC, beta hemolytic
Twisted bread: DNAse, dornase
Muffins with phosphate: Streptokinase, converts plasminogen to plasmin, fibrinolytic
_..

Lady with antibody tongs: Check ASO titer
Group B Strep
_aka strep agalactiae.,
_..

Beta light bulb: Beta hemolytic
Baci hound licking helmet; baby resistant from being licked: Bacitracin resistant
GBS: Hydrolyzes sodium hippurate, positive hippurate test
Helmet on hippo: Encapsulated
Space camp with golden staff: Positive CAMP Test Enhances hemolysis by Staph aureus
Red arrow head: zone of hemolysis on petri dish

_..

Meningitis helmet on baby: Meningitis in newborns
Red baby cloth: Sepsis in newborns
Baby coughing: Pneumonia in newborns
_..

Tunnel: baby gets GBS via vaginal delivery
35 wk: Screen pregnant mothers at 35 weeks
_..

Pencil stabbing into mother ship: Treat mother with intrapartum penicillin
Strep pneumo and viridans
_..

green a knight tournament: Alpha hemolytic
Strep pneumo
_..

armor: polysaccharide capsule
chin not protected: optochin sensitive
2 lances: Gram positive cocci, "lancet shaped"
mud on horse legs: Bile sensitive
_..

shield with IgA dimer: IgA protease is major virulence factor
_..

esquire mopping: Causes "MOPS" -meningitis -otitis media -pneumonia -sinusitis
#1 sign: #1 cause of mops
armor covered with rust: Produces lower lobal pneumonia with "rusty sputum"
_..

sickle: Increased risk in sickle cell population or if asplenic
_..

3 axes: Ceftriaxone may be used for treatment
crows: Macrolides commonly used for uncomplicated cases
_..

Adult M, children G:
Polysaccharide vaccine in adults. Produces IgM response, T independent response
Conjugate vaccine for children. Produces IgG response
Strep viridans
_..

no armor: no capsule
protect face with mask: Optochin resistant
bile resistant boot: Bile resistant
_..

strep mutans and bovis
_..

donkey with yellow teeth: Causes dental carries
pope's damaged hat and plate on arm: Adheres to fibrin-platelet aggregates in damaged heart valves (mitral valve)
deck of cards: Synthesizes dextrans from glucose, glue sticks to platelets
Enterococcus
_..

formerly part of Group D Strep
Enterococcus: intestine, coccus; different from enterobacter, gm - rod
Resist bili club, bile resistant boots: bile resistant
6.5%: grows on 6.5% NaCl
_..

California sign, more people: E. Faecalis - More prevalent, less pathogenic
Fees, buffer guy: E. Faecium - Less prevalent, more pathogenic/dangerous
_..

Do U heart trees: May cause of endocarditis, UTI, and biliary tree infection (insoluble in bile)
_..

Resist van: Vancomycin resistant nosocomial infection
Police line, department, tiger strip: daptomycin, linezolid, tigecyclin
Last updated